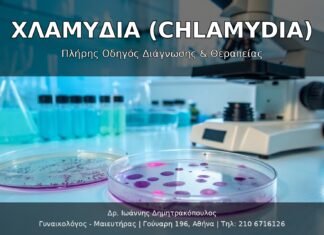
Χλαμύδια (Chlamydia): Πλήρης Οδηγός Διάγνωσης, Θεραπείας & Πρόληψης

Υγεία Κόλπου: Πρόληψη και Αντιμετώπιση Κολπικών Λοιμώξεων
Η υγεία του κόλπου αποτελεί αναπόσπαστο κομμάτι της συνολικής ευεξίας της γυναίκας και επηρεάζει άμεσα την ποιότητα ζωής, τις σεξουαλικές σχέσεις και την αναπαραγωγική υγεία. Οι κολπικές λοιμώξεις είναι από τα πιο συχνά γυναικολογικά...
Ενδομητρίωση: Διάγνωση, Συμπτώματα και Θεραπευτικές Επιλογές
Εισαγωγή
Η ενδομητρίωση είναι μια χρόνια γυναικολογική πάθηση που επηρεάζει 1 στις 10 γυναίκες αναπαραγωγικής ηλικίας. Παρόλο που είναι συχνή, συχνά υποδιαγιγνώσκεται, με μέσο χρόνο διάγνωσης 7-10 έτη από την έναρξη των συμπτωμάτων.
Τι είναι η...
Προληπτικός Γυναικολογικός Έλεγχος: Γιατί είναι Απαραίτητος;
Εισαγωγή
Η προληπτική φροντίδα αποτελεί τον ακρογωνιαίο λίθο της γυναικείας υγείας. Ο τακτικός γυναικολογικός έλεγχος μπορεί να εντοπίσει έγκαιρα προβλήματα, να προλάβει σοβαρές παθήσεις και να διασφαλίσει την ευημερία σας.
Γιατί είναι Σημαντικός ο Προληπτικός Έλεγχος;
Πρώιμη...
Εξωσωματική Γονιμοποίηση: Ο Δρόμος προς τη Μητρότητα
Εισαγωγή
Η εξωσωματική γονιμοποίηση (IVF) αποτελεί μία από τις πιο σημαντικές εξελίξεις στην αναπαραγωγική ιατρική, προσφέροντας ελπίδα σε χιλιάδες ζευγάρια που αντιμετωπίζουν προβλήματα γονιμότητας.
Τι είναι η Εξωσωματική Γονιμοποίηση;
Η IVF είναι μια διαδικασία υποβοηθούμενης αναπαραγωγής όπου...
Εμμηνόπαυση: Συμπτώματα, Αλλαγές και Σύγχρονη Αντιμετώπιση
Εισαγωγή
Η εμμηνόπαυση είναι ένα φυσικό στάδιο στη ζωή κάθε γυναίκας που σηματοδοτεί το τέλος της αναπαραγωγικής της περιόδου. Παρόλο που πρόκειται για μια φυσιολογική διαδικασία, τα συμπτώματα και οι αλλαγές που τη συνοδεύουν μπορούν...
Γυναικεία Ευεξία και Αυτοπεποίθηση: Ο Ρόλος της Σύγχρονης Γυναικολογίας στην Ποιότητα Ζωής
Εισαγωγή
Η γυναικεία υγεία δεν αφορά μόνο την απουσία νόσων, αλλά την ολιστική προσέγγιση της σωματικής, ψυχολογικής και σεξουαλικής ευημερίας. Στο σύγχρονο Vital Womanhood Clinic, κατανοούμε ότι κάθε γυναίκα αξίζει να αισθάνεται δυνατή, υγιής και...
Σεξουαλικώς Μεταδιδόμενες Λοιμώξεις & Εγκυμοσύνη: Προστασία Μητέρας & Βρέφους
Πλήρης οδηγός για STIs κατά την εγκυμοσύνη - Επιπτώσεις, έλεγχος και προστασία μητέρας-βρέφους από το Δρ. Ιωάννη Δημητρακόπουλο.
HPV & Κονδυλώματα (Genital Warts): Πλήρης Οδηγός Διάγνωσης, Θεραπείας & Εμβολιασμού
Εισαγωγή: Τι είναι ο Ιός HPV και τα Κονδυλώματα;
Ο Ιός των Ανθρώπινων Θηλωμάτων (Human Papillomavirus - HPV) είναι μία από τις πιο συχνές σεξουαλικώς μεταδιδόμενες λοιμώξεις παγκοσμίως. Εκτιμάται ότι πάνω από το 80% του...
Χλαμύδια (Chlamydia): Πλήρης Οδηγός Διάγνωσης, Θεραπείας & Πρόληψης
Εισαγωγή: Τι είναι η Χλαμύδια;
Η χλαμύδια (Chlamydia trachomatis) είναι μία από τις πιο κοινές σεξουαλικώς μεταδιδόμενες λοιμώξεις (STIs) παγκοσμίως. Σύμφωνα με τον Παγκόσμιο Οργανισμό Υγείας (WHO), εκτιμάται ότι πάνω από 130 εκατομμύρια νέες μολύνσεις...
Η Ολοκληρωμένη Προσέγγιση στην Αισθητική Ιατρική: Οδηγός για τις Σύγχρονες Θεραπείες
Ανακαλύψτε τις πιο εξελιγμένες θεραπείες αισθητικής ιατρικής και πλαστικής χειρουργικής. Ολοκληρωμένος οδηγός για PRP, ThermiVa, κολπική αναζωογόνηση, facelift, αυξήτικη στήθους και πολλά άλλα.